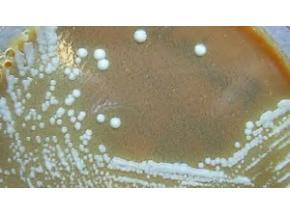

Press release
Global Tularemia Sales Market Report 2017
The Global Tularemia Sales Market Report 2017 is a professional and in-depth study on the current state of the Tularemia industry.Firstly, the report provides a basic overview of the industry including definitions, classifications, applications and industry chain structure. The Tularemia market analysis is provided for the international market including development history, competitive landscape analysis, and major regions’ development status.
Secondly, development policies and plans are discussed as well as manufacturing processes and cost structures. This report also states import/export, supply and consumption figures as well as cost, price, revenue and gross margin by regions (United States, EU, China and Japan), and other regions can be added.
Then, the report focuses on global major leading industry players with information such as company profiles, product picture and specification, capacity, production, price, cost, revenue and contact information. Upstream raw materials, equipment and downstream consumers analysis is also carried out. What’s more, the Tularemia industry development trends and marketing channels are analyzed.
Finally, the feasibility of new investment projects is assessed, and overall research conclusions are offered.
In a word, the report provides major statistics on the state of the industry and is a valuable source of guidance and direction for companies and individuals interested in the market.
In this report, the global Tularemia market is valued at USD XX million in 2016 and is expected to reach USD XX million by the end of 2022, growing at a CAGR of XX% between 2016 and 2022.
Geographically, this report split global into several key Regions, with sales (K Units), revenue (Million USD), market share and growth rate of Tularemia for these regions, from 2012 to 2022 (forecast), covering
United States
China
Europe
Japan
Korea
Taiwan
Global Tularemia market competition by top manufacturers/players, with Tularemia sales volume, Price (USD/Unit), revenue (Million USD) and market share for each manufacturer/player; the top players including
Nicholas Piramal
Alkem
Glaxo Smithkline
Bayer AG
Ranbaxy Laboratories
Cipla Inc
Zydus Cadila
Dr. Reddy's Lab
Glenmark Pharmaceuticals
Lupin Limited
Pfizer Inc
......
On the basis of product, this report displays the sales volume (K Units), revenue (Million USD), product price (USD/Unit), market share and growth rate of each type, primarily split into
Ulceroglandular Tularemia
Glandular Tularemia
Oculoglandular Tularemia
Oropharyngeal Tularemia
Pneumonic Tularemia
Others
On the basis on the end users/applications, this report focuses on the status and outlook for major applications/end users, sales volume, market share and growth rate of Tularemia for each application, including
Hospitals and Clinics
Academic and Research Centers
Others
To get a free professional report sample, please email to tinaning@qyresearch.com or Browse our detailed product page: https://www.qyresearcheurope.com/goods-696722.html
Table of contents:
1 Tularemia Market Overview
2 Global Tularemia Competition by Players/Suppliers, Type and Application
3 United States Tularemia (Volume, Value and Sales Price)
4 China Tularemia (Volume, Value and Sales Price)
5 Europe Tularemia (Volume, Value and Sales Price)
6 Japan Tularemia (Volume, Value and Sales Price)
7 Korea Tularemia (Volume, Value and Sales Price)
8 Taiwan Tularemia (Volume, Value and Sales Price)
9 Global Tularemia Players/Suppliers Profiles and Sales Data
10 Tularemia Maufacturing Cost Analysis
11 Industrial Chain, Sourcing Strategy and Downstream Buyers
12 Marketing Strategy Analysis, Distributors/Traders
13 Market Effect Factors Analysis
14 Global Tularemia Market Forecast (2017-2022)
15 Research Findings and Conclusion
16 Appendix
List of Tables and Figures
Figure Product Picture of Tularemia
Figure Global Tularemia Sales Volume Comparison (K Units) by Type (2012-2022)
Figure Global Tularemia Sales Volume Market Share by Type (Product Category) in 2016
Figure Ulceroglandular Tularemia Product Picture
Figure Glandular Tularemia Product Picture
Figure Oculoglandular Tularemia Product Picture
Figure Oropharyngeal Tularemia Product Picture
Figure Pneumonic Tularemia Product Picture
Figure Others Product Picture
Figure Global Tularemia Sales Comparison (K Units) by Application (2012-2022)
Figure Global Sales Market Share of Tularemia by Application in 2016
Figure Hospitals and Clinics Examples
Figure Academic and Research Centers Examples
Figure Others Examples
......
Related Reports:
Europe Tularemia Sales Market Report 2017
China Tularemia Sales Market Report 2017
USA Tularemia Sales Market Report 2017
Korea Tularemia Sales Market Report 2017
Japan Tularemia Sales Market Report 2017
India Tularemia Sales Market Report 2017
Contact Details:
Tina| Sales Managers
Company Name: QYResearch CO.,LIMITED | focus on Market Survey and Research
Email: tinaning@qyresearch.com Tel: 0086-20-22093278(CN)
Web: http://www.qyresearchglobal.com/
QYResearch established in 2007, focus on custom research, management consulting, IPO consulting, industry chain research, data base and seminar services. The company owned a large basic data base (such as National Bureau of statistics database, Customs import and export database, Industry Association Database etc), experts resources (included energy automotive chemical medical ICT consumer goods etc industries experts who own more than 10 years experiences on marketing or R&D), professional survey team (the team member with more than 3 years market survey experience and more than 2 years depth expert interview experience),Excellent data analysis team (SPSS statistics and PPT graphics process team); QYResearch has always pursuit product quality, adhere to the quality is the soul of business.
Room 2311 VILI International Building No.167 Linhe West Road Tianhe District
This release was published on openPR.
Permanent link to this press release:
Copy
Please set a link in the press area of your homepage to this press release on openPR. openPR disclaims liability for any content contained in this release.
You can edit or delete your press release Global Tularemia Sales Market Report 2017 here
News-ID: 690479 • Views: …
More Releases for Sales
Sales Council Recognises Twib as 'Best Sales Tracking App' for Revolutionary Fie …
Mumbai - August 18, 2025 - Twib [https://twib.online/], a leading sales tracking application, has been recognised with the prestigious 'Best Sales Tracking App' title by the Sales Council, acknowledging its groundbreaking contribution to revolutionizing field sales management across diverse markets. This coveted recognition positions Twib as the premier choice for businesses seeking comprehensive sales tracking solutions in today's rapidly evolving digital marketplace.
Industry Recognition Validates Innovation Leadership
The Sales Council's recognition underscores…
Global Satellite Market 2019 Sales Volume, Sales Price, Sales Revenue Analysis a …
Global Satellite Market report explores manufacturer’s competitive scenario and provides market share for all major players of this market based on production capacity, sales, revenue, geographical presence and other major factors. The report also covers import/export data across all major regions covered in this report
This report studies the global Satellite market status and forecast, categorizes the global Satellite market size (value & volume) by manufacturers, type, application, and region. This…
Biochips Market Sales Volume, Sales Price, Sales Revenue Analysis
The global biochips market was valued at US$ 7,026.4 million in 2016 and is expected to witness a robust CAGR of 16.2% over the forecast period (2017 – 2025).
Biochips are miniaturized laboratories, which can perform simultaneous biochemical reactions. On the basis of functionality, biochips are classified as DNA chips, protein chips, lab-on-a-chips, and tissue and cell arrays. DNA chips, biochips or DNA microarrays consists of a microscope slide made of…
Shock Wave Therapy Devices Market Sales Volume, Sales Price, Sales Revenue Analy …
Shock wave therapy also called extracorporeal shock wave therapy (ESWT) is a non-invasive treatment that is used in wide areas of medical field that includes physical therapy, orthopedics, cardiology, and urology. Shock wave therapy is an alternative treatment for orthopedic surgeries. The term extracorporeal signifies the external shock generation, and the resultant shock waves are then transmitted to the internal parts of the body via intermediate pads through the skin.…
Insulin Pumps Market Sales Volume, Sales Price, Sales Revenue Analysis
Insulin pump is a portable device attached to the body that continuously delivers preset amounts of short or rapid acting insulin in the body to control diabetes. Insulin therapy is required in type 1 diabetes and sometime in type 2 diabetes. It serves as an effective alternative to insulin injections. Furthermore, insulin pump delivers the insulin according to the need of body as basal rate, where small amount of insulin…
Global Small Beer Market 2018 Sales Volume, Sales Price, Sales Revenue Analysis …
Small Beer Research Report covers the Major Key Players data analysis that includes market revenue, gross rate, profit, and distribution market etc., a competitive analysis that will help to know more about market competitors. This research report covers all the major regions and countries worldwide, that will help to know about regional growth rate (revenue) status, includes market size, the future forecast for next 5 years.
The Small Beer market was…